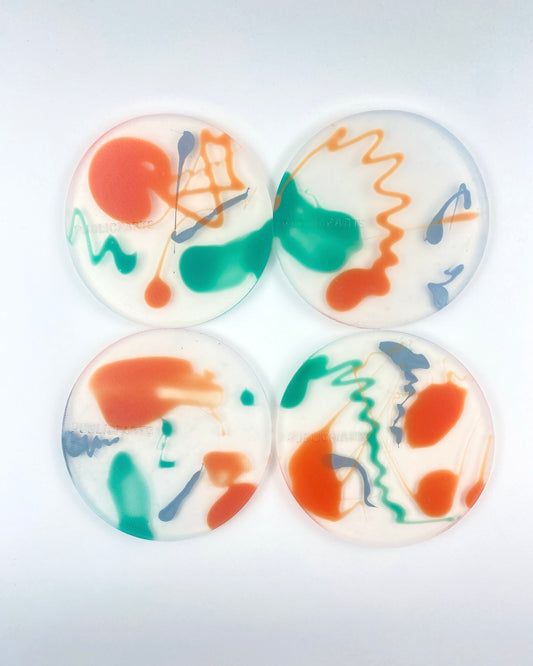
Flux — Signal · Limited Edition Silicone Coaster Set (Heat-Reactive)
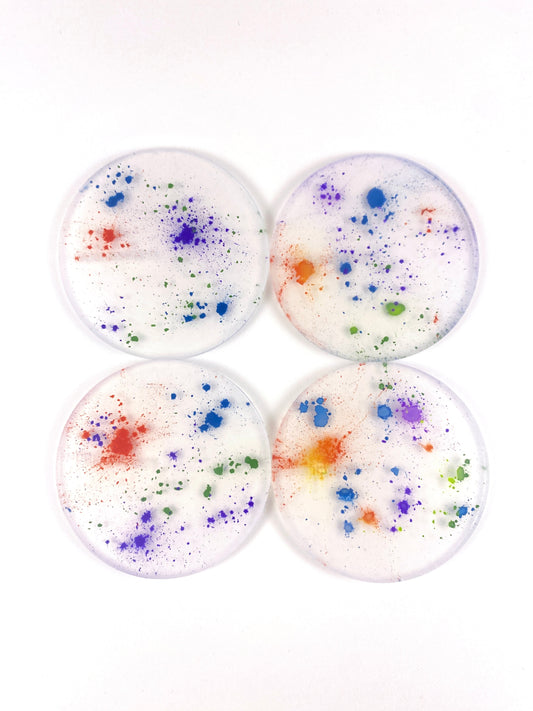
Spectra - Powder Dust · Silicone Coaster Set (Heat-Reactive)

-
Flux — Verdant · Limited Edition Silicone Coaster Set (Heat-Reactive)
Regular price £65.00 GBPRegular price -
Flux — Signal · Limited Edition Silicone Coaster Set (Heat-Reactive)
Regular price £65.00 GBPRegular price -
Spectra - Heat Clash · Orange/Pink Silicone Coaster Set (Heat-Reactive)
Regular price £55.00 GBPRegular price -
Spectra - Powder Dust · Silicone Coaster Set (Heat-Reactive)
Regular price £55.00 GBPRegular price -
Studio - Chromatic · Silicone Coaster Set (Heat-Reactive)
Regular price £42.00 GBPRegular price -
Studio - Monochrome · Silicone Coaster Set (Heat-Reactive)
Regular price £42.00 GBPRegular price